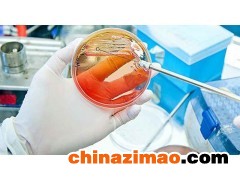

|
|
公司基本資料信息
|
|||||||||||||||||||||||||||||
產(chǎn)品詳細(xì)說明
kord-valmark培養(yǎng)碟現(xiàn)貨促銷
kord-valmark全國(guó)代理現(xiàn)貨促銷,Kord-Valmark 2900現(xiàn)貨促銷,Kord四分格培養(yǎng)碟現(xiàn)貨促銷,2902培養(yǎng)碟皿現(xiàn)貨促銷,Kord穩(wěn)定疊放4分格培養(yǎng)皿現(xiàn)貨促銷,Mono Plate Deep Dish ISO Mark現(xiàn)貨促銷,KordMono Plate with ISO MARK現(xiàn)貨促銷,Kord Stackable Petri Dishes 2912現(xiàn)貨促銷,Kord 150x15mm培養(yǎng)皿現(xiàn)貨促銷,堆疊培養(yǎng)皿現(xiàn)貨促銷
Kord 100 x 15四板培養(yǎng)皿
·設(shè)計(jì)用于在同一環(huán)境中同時(shí)研究生物體
·四個(gè)標(biāo)記的隔間,便于識(shí)別
·用于定向的ISO標(biāo)記目標(biāo)
·蓋子上的角度減小,確保自動(dòng)化設(shè)備的易用性
·一般微生物用一次性(一次性)聚苯乙烯培養(yǎng)皿
·由純聚苯乙烯模制而成
·光學(xué)透明
·輻射滅菌
·如果套管未打開,內(nèi)容物無菌
·通風(fēng)肋允許空氣自由流通,減少孵化過程中的冷凝
·一致的平整度允許均勻的介質(zhì)分布
·喇叭形蓋裙和方形角便于單手操作,尤其是帶手套時(shí)
·可根據(jù)要求提供滅菌處理證書
·按批次和SKU編號(hào)可追溯•可根據(jù)要求提供合規(guī)證書
庫(kù)爾德™ 100 x 15三平板培養(yǎng)皿
·設(shè)計(jì)用于在同一環(huán)境中同時(shí)研究生物體
·三個(gè)有標(biāo)記的隔間,便于識(shí)別
·用于定向的ISO標(biāo)記目標(biāo)
·蓋子上的角度減小,確保自動(dòng)化設(shè)備的易用性
·一般微生物用一次性(一次性)聚苯乙烯培養(yǎng)皿
·由純聚苯乙烯模制而成
·光學(xué)透明
·輻射滅菌
·如果套管未打開,內(nèi)容物無菌
·通風(fēng)肋允許空氣自由流通,減少孵化過程中的冷凝
·一致的平整度允許均勻的介質(zhì)分布
·喇叭形蓋裙和方形角便于單手操作,尤其是帶手套時(shí)
·可根據(jù)要求提供滅菌處理證書
·按批次和SKU編號(hào)可追溯
·應(yīng)要求提供合規(guī)證書
100 x 15 mm可堆疊培養(yǎng)皿
kord-valmark全國(guó)代理現(xiàn)貨促銷,Kord-Valmark 2900現(xiàn)貨促銷,Kord四分格培養(yǎng)碟現(xiàn)貨促銷,2902培養(yǎng)碟皿現(xiàn)貨促銷,Kord穩(wěn)定疊放4分格培養(yǎng)皿現(xiàn)貨促銷,Mono Plate Deep Dish ISO Mark現(xiàn)貨促銷,KordMono Plate with ISO MARK現(xiàn)貨促銷,Kord Stackable Petri Dishes 2912現(xiàn)貨促銷,Kord 150x15mm培養(yǎng)皿現(xiàn)貨促銷,堆疊培養(yǎng)皿現(xiàn)貨促銷
ap48--Neuro Probe 48孔微趨化室 http://www.chem17.com/st421561/product_35013676.html
高通量單細(xì)胞流變學(xué)測(cè)試 http://www.chem17.com/st420642/product_35407556.html
Kord 2906穩(wěn)定疊放培養(yǎng)碟皿現(xiàn)貨促銷 http://cn.jzjxqm.com/gying/202012/19/10528465.html
微納支架3D打印機(jī) http://www.chem17.com/st430984/product_35467703.html
Concentric Bottom Ring培養(yǎng)皿現(xiàn)貨促銷 http://www.chem17.com/st420642/product_35477207.html
高通量單細(xì)胞流變學(xué)測(cè)試 http://www.chem17.com/st420642/product_35407556.html
Kord 2906穩(wěn)定疊放培養(yǎng)碟皿現(xiàn)貨促銷 http://cn.jzjxqm.com/gying/202012/19/10528465.html
微納支架3D打印機(jī) http://www.chem17.com/st430984/product_35467703.html
Concentric Bottom Ring培養(yǎng)皿現(xiàn)貨促銷 http://www.chem17.com/st420642/product_35477207.html
共0條 [查看全部] 相關(guān)評(píng)論
更多»本企業(yè)其它產(chǎn)品